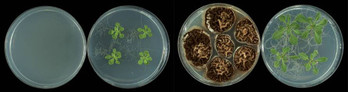
quark

Euskal Herria
Ribera derecha de Burdeos, caladero de ideas para la construcción de viviendas

Euskal Herria
Ambulancias de Osakidetza, un servicio de camino a urgencias

Euskal Herria
Una acción de denuncia de la colaboración de CAF con Israel acaba con un detenido en Bilbo

Euskal Herria
Mikel Zabalza gogoan: «Memoriaren herria gara, ezkutuan gorde nahi dutena argitaratuko duena»

Euskal Herria